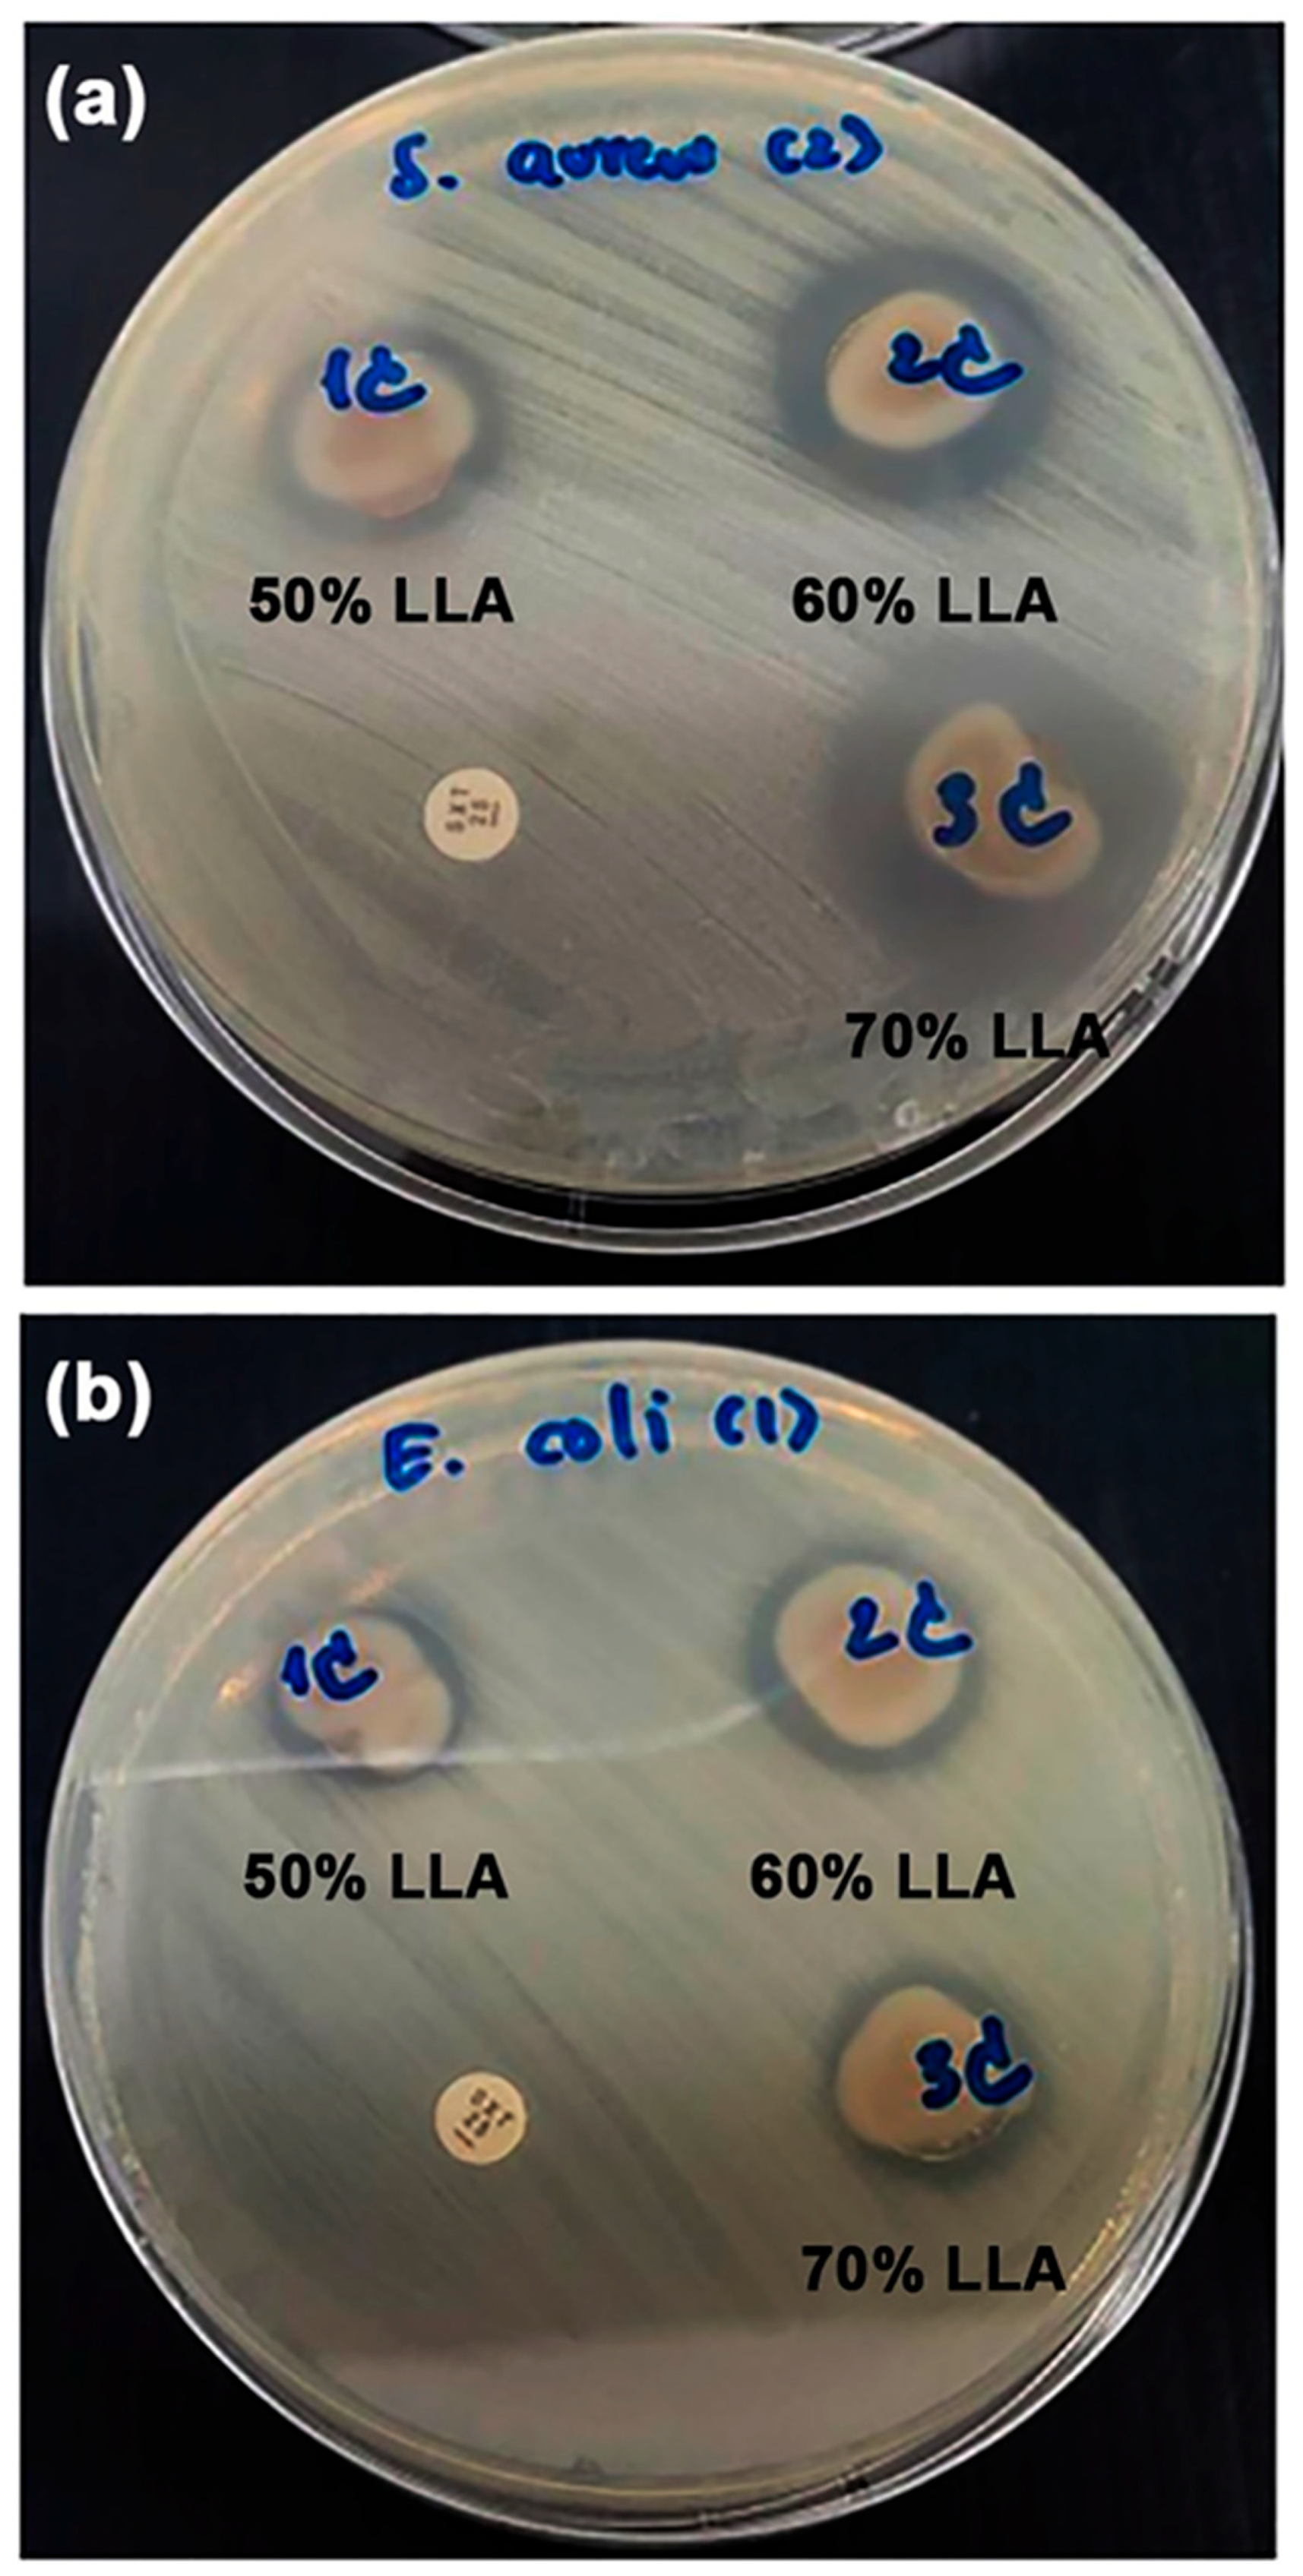
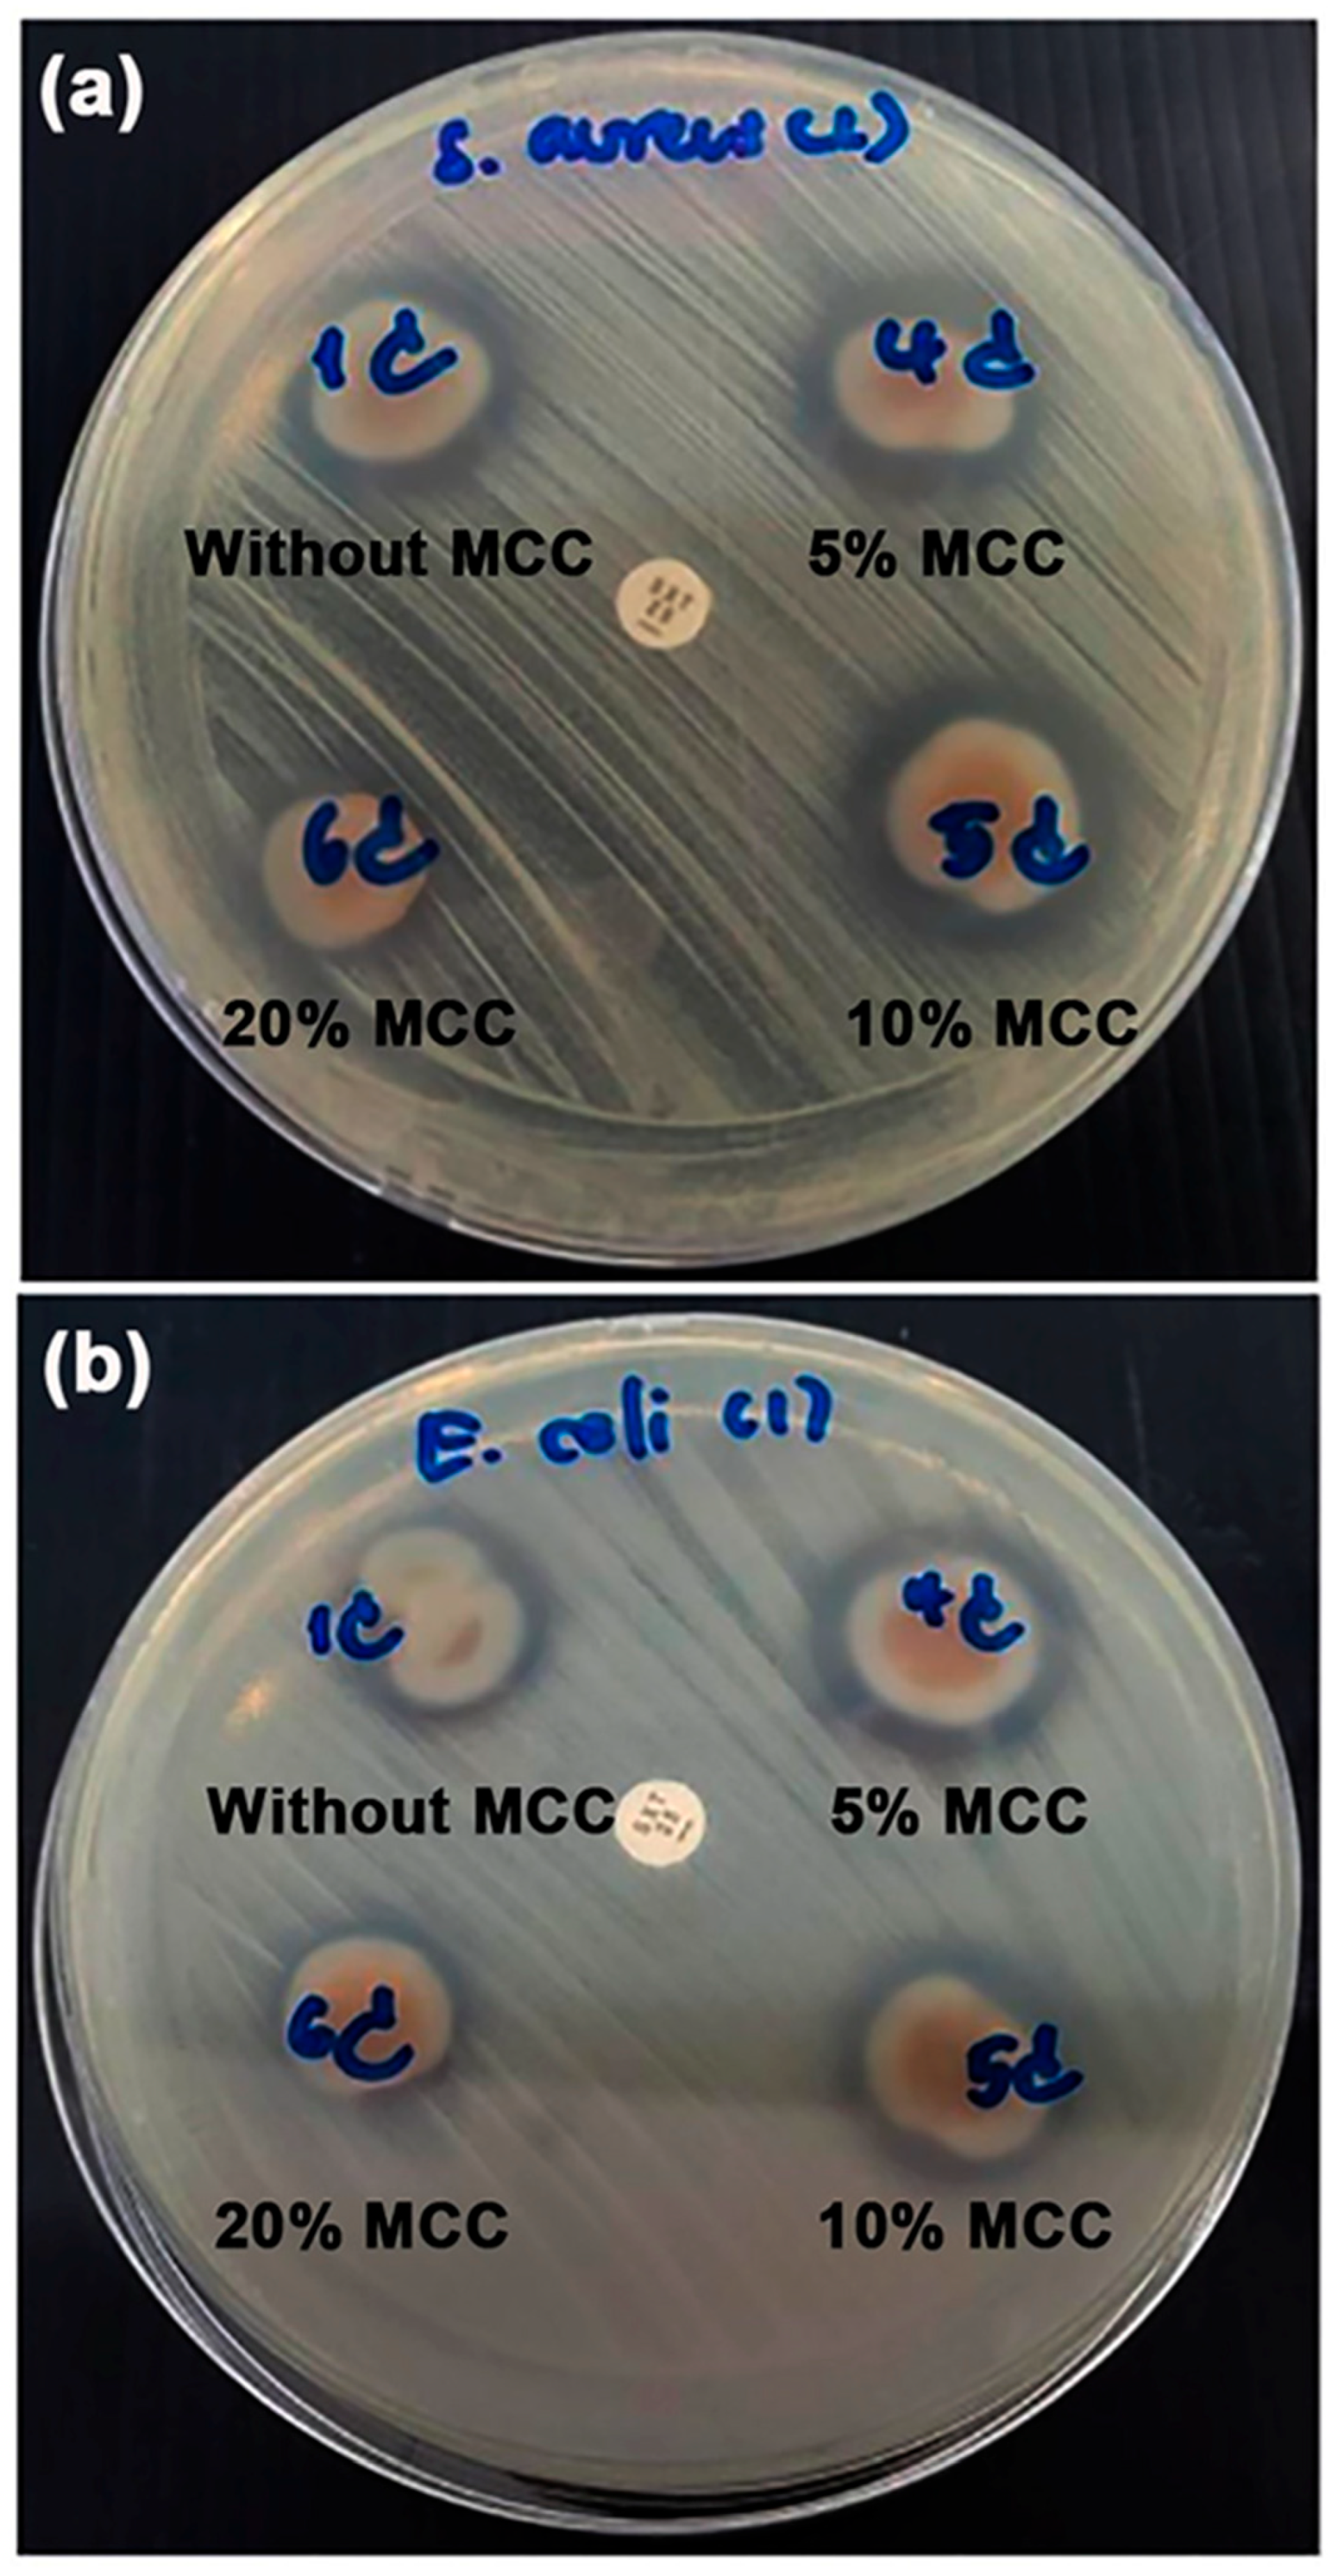

Thermo-Compression of Thermoplastic Chitosan Films Reinforced with Microcrystalline Cellulose for Antibacterial Food Packaging Application
Abstract
1. Introduction
2. Materials and Methods
2.1. Materials
2.2. Preparation of Thermoplastic Chitosan/MCC Composite Films
2.3. Characterization of TPC and TPC/MCC Composite Films
2.4. Statistical Analysis
3. Results and Discussion
3.1. The Effect of LLA Content on Properties of Thermo-Compressed TPC Films
3.1.1. ATR-FTIR Analysis
3.1.2. Thermal Decomposition
3.1.3. Phase Morphology
3.1.4. Crystalline Structures
3.1.5. Tensile Properties
3.1.6. Moisture Content, Water Dissolution, and Surface Wettability
3.1.7. Film Opacity and Antibacterial Activity
3.2. The Effect of MCC Content on Properties of Thermo-Compressed TPC/MCC Films
3.2.1. ATR-FTIR Analysis
3.2.2. Thermal Decomposition
3.2.3. Phase Morphology
3.2.4. Crystalline Structures
3.2.5. Tensile Properties
3.2.6. Moisture Content, Surface Wettability, and Water Dissolution
3.2.7. Film Opacity and Antibacterial Activity
4. Conclusions
Supplementary Materials
Author Contributions
Funding
Institutional Review Board Statement
Data Availability Statement
Conflicts of Interest
References
- Tripathi, N.; Misra, M.; Mohanty, A.K. Durable polylactic acid (PLA)-based sustainable engineered blends and biocomposites: Recent developments, challenges, and opportunities. ACS Eng. Au 2021, 1, 7–38. [Google Scholar] [CrossRef]
- Andreeßen, C.; Steinbuchel, A. Recent developments in non-biodegradable biopolymers: Precursors, production processes, and future perspectives. Appl. Microbiol. Biotechnol. 2019, 103, 143–157. [Google Scholar] [CrossRef]
- Silva, R.R.A.; Marques, C.S.; Arruda, T.R.; Teixeira, S.C.; de Oliveira, T.V. Biodegradation of polymers: Stages, measurement, standards and prospects. Macromol 2023, 3, 371–399. [Google Scholar] [CrossRef]
- Jariyasakoolroj, P.; Leelaphiwat, P.; Harnkarnsujarit, N. Advances in research and development of bioplastic for food packaging. J. Sci. Food Agric. 2020, 100, 5032–5045. [Google Scholar] [CrossRef]
- Kakadellis, S.; Harris, Z.M. Don’t scrap the waste: The need for broader system boundaries in bioplastic food packaging life cycle assessment—A critical review. J. Clean. Prod. 2020, 274, 122831. [Google Scholar] [CrossRef]
- Zhao, X.; Cornish, K.; Vodovotz, Y. Narrowing the gap for bioplastic use in food packaging: An update. Environ. Sci. Technol. 2020, 54, 4712–4732. [Google Scholar] [CrossRef]
- Cheng, J.; Gao, R.; Zhu, Y.; Lin, Q. Applications of biodegradable materials in food packaging: A review. Alex. Eng. J. 2024, 91, 70–83. [Google Scholar] [CrossRef]
- Ambaye, T.G.; Vaccari, M.; Prasad, S.; Hullebusch, E.D.; Rtimi, S. Preparation and applications of chitosan and cellulose composite materials. J. Environ. Manag. 2022, 301, 113850. [Google Scholar] [CrossRef] [PubMed]
- Strnad, S.; Zemljič, L.F. Cellulose–chitosan functional biocomposites. Polymers 2023, 15, 425. [Google Scholar] [CrossRef]
- Jiang, A.; Patel, R.; Padhan, B.; Palimkar, S.; Galgali, P.; Adhikari, A.; Varga, I.; Patel, M. Chitosan based biodegradable composite for antibacterial food packaging application. Polymers 2023, 15, 2235. [Google Scholar] [CrossRef]
- Gao, W.; Mu, B.; Yang, F.; Li, Y.; Wang, A. Green preparation of licorice flavonoids/ZnO/attapulgite nanocomposites for multifunctional chitosan-based food packaging films. LWT 2024, 201, 116273. [Google Scholar] [CrossRef]
- Qu, T.; Wang, X.; Zhang, F. Antibacterial food packaging with chitosan and cellulose blends for food preservation. Polymers 2025, 17, 1850. [Google Scholar] [CrossRef]
- Dhalsamant, K.; Dalai, A.; Pattnaik, F.; Acharya, B. Biodegradable carbohydrate-based films for packaging agricultural products—A review. Polymers 2025, 17, 1325. [Google Scholar] [CrossRef] [PubMed]
- Ji, Q.; Su, L.; Boateng, I.D.; Li, Z.; Zhou, C.; Liu, X.; Ma, Y. Preparation of chitosan/peanut shell nano-lignocellulose (CS/NLC) composite film and its preservation effect on cherry tomato and blueberry. Ind. Crops Prod. 2025, 228, 120881. [Google Scholar] [CrossRef]
- Matet, M.; Heuzey, M.-C.; Pollet, E.; Ajji, A.; Avérous, L. Innovative thermoplastic chitosan obtained by thermo-mechanical mixing with polyol plasticizers. Carbohydr. Polym. 2013, 95, 241–251. [Google Scholar] [CrossRef]
- Zhang, Y.; Liu, B.-L.; Wang, L.-J.; Deng, Y.-H.; Zhou, S.-Y.; Feng, J.-W. Preparation, structure and properties of acid aqueous solution plasticized thermoplastic chitosan. Polymers 2019, 11, 818. [Google Scholar] [CrossRef]
- Dou, X.; Li, Q.; Wu, Q.; Duan, L.; Zhou, S.; Zhang, Y. Effects of lactic acid and mixed acid aqueous solutions on the preparation, structure and properties of thermoplastic chitosan. Eur. Polym. J. 2020, 134, 109850. [Google Scholar] [CrossRef]
- Hanafy, N.A.; Leporatti, S.; El-Kemary, M.A. Mucoadhesive hydrogel nanoparticles as smart biomedical drug delivery system. Appl. Sci. 2019, 9, 825. [Google Scholar] [CrossRef]
- Cheng, J.; Gao, M.; Yang, L.; Zhang, L.; Zhu, B. Coral-inspired “nanotentaclization” porous composite gel for efficient removal of Lead (II) from aqueous solution. Mater. Des. 2020, 195, 109072. [Google Scholar] [CrossRef]
- Yang, J.; Dahlstrom, C.; Edlund, H.; Lindman, B.; Norgren, M. pH-responsive cellulose–chitosan nanocomposite films with slow release of chitosan. Cellulose 2019, 26, 3763–3776. [Google Scholar] [CrossRef]
- Di Liberto, E.A.; Dintcheva, N.T. Biobased films based on chitosan and microcrystalline cellulose for sustainable packaging applications. Polymers 2024, 16, 568. [Google Scholar] [CrossRef]
- Rico, M.; Rodríguez-Llamazares, S.; Barral, L.; Bouza, R.; Montero, B. Processing and characterization of polyols plasticized-starch reinforced with microcrystalline cellulose. Carbohydr. Polym. 2016, 149, 83–93. [Google Scholar] [CrossRef] [PubMed]
- Deshmukh, R.K.; Tripathi, S.; Kumar, P.; Gaikwad, K.K. Enhanced heat sealability and barrier performance of guar gum/polyvinyl alcohol based on biocomposite film reinforced with micro-fibrillated cellulose for packaging application. Polym. Bull. 2025, 82, 3755–3783. [Google Scholar] [CrossRef]
- Schmid, M.; Reichert, K.; Hammann, F.; Stabler, A. Storage time-dependent alteration of molecular interaction-property relationships of whey protein isolate-based films and coatings. J. Mater. Sci. 2015, 50, 4396–4404. [Google Scholar] [CrossRef]
- Gao, C.; Pollet, E.; Avérous, L. Innovative plasticized alginate obtained by thermo-mechanical mixing: Effect of different biobased polyols systems. Carbohydr. Polym. 2017, 157, 669–676. [Google Scholar] [CrossRef]
- Hasheminya, S.-M.; Mokarram, R.R.; Ghanbarzadeh, B.; Hamishekar, H.; Kafil, H.S.; Dehghannya, J. Development and characterization of biocomposite films made from kefiran, carboxymethyl cellulose and Satureja Khuzestanica essential oil. Food Chem. 2019, 289, 443–452. [Google Scholar] [CrossRef] [PubMed]
- Tang, Z.; Fan, F.; Chu, Z.; Fan, C.; Qin, Y. Barrier properties and characterizations of poly(lactic acid)/ZnO nanocomposites. Molecules 2020, 25, 1310. [Google Scholar] [CrossRef]
- Bekbayeva, L.; Mun, G.A.; Yermukhambetova, B.B.; Negim, E.-S.; Irmukhametova, G.; Al Azzam, K.M.; Nechipurenko, S.V.; Efremov, S.A.; Yermaganbetov, M.; Samy, M. Synthesis and characterization of biodegradable polymer blends based on chitosan. Polymers 2025, 17, 1853. [Google Scholar] [CrossRef]
- Yasmeen, S.; Kabiraz, M.K.; Saha, B.; Qadir, M.R.; Gafur, M.A.; Masum, S.M. Chromium (VI) ions removal from tannery effluent using chitosan-microcrystalline cellulose composite as adsorbent. Int. Res. J. Pure Appl. Chem. 2016, 10, 1–14. [Google Scholar] [CrossRef]
- Zhai, X.; Zhang, X.; Ao, H.; Yin, Y.; Li, X.; Ren, D. Preparation and characterization of whey protein isolate/chitosan/microcrystalline cellulose composite films. Packag. Technol. Sci. 2021, 34, 589–599. [Google Scholar] [CrossRef]
- Benali, Y.; Mabrouki, N.; Agougui, H.; Jabli, M.; Majdoub, H.; Predoi, D.; Ciobanu, S.; Iconaru, S.L.; Ţălu, S.; Boughzala, K. A new porous composite hydroxyapatite/chitosan/microcrystalline-cellulose: Synthesis, characterization and application to the adsorption of Eriochrome Black T. Polym. Bull. 2024, 81, 16875–16902. [Google Scholar] [CrossRef]
- Chien, N.V.; Yen, D.H.; Phuong, H.T.; Trang, P.Q.; Diep, N.T.; Huy, T.H.; Phuong, P.T.; Tuyet, P.A. Preparation of bioplastic materials based on thermoplastic chitosan and starch by melting mixing method. Vietnam J. Chem. 2024, 62, 1–7. [Google Scholar] [CrossRef]
- Stroparo, E.C.; Mollinari, K.C.; de Souza, K.V. Use of chitosan in the remediation of water from purification of biodiesel. Polímeros 2018, 28, 400–405. [Google Scholar] [CrossRef]
- Alrman, K.H.; Alhariri, S.; Al-Bakri, I. Ultrafiltration membrane based on chitosan/adipic acid: Synthesis, characterization and performance on separation of methylene blue and reactive yellow-145 from aqueous phase. Heliyon 2024, 10, e31055. [Google Scholar] [CrossRef]
- Xu, J.; Xia, R.; Zheng, L.; Yuan, T.; Sun, R. Plasticized hemicelluloses/chitosan-based edible films reinforced by cellulose nanofiber with enhanced mechanical properties. Carbohydr. Polym. 2019, 224, 115164. [Google Scholar] [CrossRef] [PubMed]
- Zhang, H.; Yang, S.; Fang, J.; Deng, Y.; Wang, D.; Zhao, Y. Optimization of the fermentation conditions of Rhizopus japonicus M193 for the production of chitin deacetylase and chitosan. Carbohydr. Polym. 2014, 101, 57–67. [Google Scholar] [CrossRef] [PubMed]
- Weng, R.; Chen, L.; Lin, S.; Zhang, H.; Wu, H.; Liu, K.; Cao, S.; Huang, L. Preparation and characterization of antibacterial cellulose/chitosan nanofiltration membranes. Polymers 2017, 9, 116. [Google Scholar] [CrossRef]
- Madian, N.G.; El-Ashmanty, B.A.; Abdel-Rahim, H.K. Improvement of chitosan films properties by blending with cellulose, honey and curcumin. Polymers 2023, 15, 2587. [Google Scholar] [CrossRef]
- Wadkin-Snaith, D.; Mulheran, P.A.; Johnston, K. The impact of plasticisers on crystal nucleation, growth and melting in linear polymers. Polymer 2024, 304, 127095. [Google Scholar] [CrossRef]
- Srinivasa, P.C.; Ramesh, M.N.; Kumar, K.R.; Tharanathan, N. Properties of chitosan films prepared under different drying conditions. J. Food Eng. 2004, 63, 79–85. [Google Scholar] [CrossRef]
- Mathew, S.; Brahmakumar, M.; Abraham, T. Microstructural imaging and characterization of the mechanical, chemical, thermal, and swelling properties of starch-chitosan blend films. Biopolymers 2006, 82, 176–187. [Google Scholar] [CrossRef]
- Kaya, M.; Seyyar, O.; Baran, T.; Turkes, T. Bat guano as new and attractive chitin and chitosan source. Front. Zool. 2014, 11, 59. [Google Scholar] [CrossRef]
- Sun, L.; Sun, J.; Chen, L.; Niu, P.; Yang, X.; Guo, Y. Preparation and characterization of chitosan film incorporated with thinned young apple polyphenols as an active packaging material. Carbohydr. Polym. 2017, 163, 81–91. [Google Scholar] [CrossRef]
- Lin, Y.; Bilotti, E.; Bastiaansen, C.W.M.; Peijs, T. Transparent semi-crystalline polymeric materials and their nanocomposites: A review. Polym. Eng. Sci. 2020, 60, 2351–2376. [Google Scholar] [CrossRef]
- Qi, L.; Xu, Z.; Jiang, X.; Hu, C.; Zou, X. Preparation and antibacterial activity of chitosan nanoparticles. Carbohydr. Res. 2004, 339, 2693–2700. [Google Scholar] [CrossRef] [PubMed]
- Li, K.; Guan, G.; Zhu, J.; Wu, H.; Sun, Q. Antibacterial activity and mechanism of a laccase-catalyzed chitosan–gallic acid derivative against Escherichia coli and Staphylococcus aureus. Food Control 2019, 96, 234–243. [Google Scholar] [CrossRef]
- Chandrasekaran, M.; Kim, K.D.; Chun, S.C. Antibacterial activity of chitosan nanoparticles: A review. Processes 2020, 8, 1173. [Google Scholar] [CrossRef]
- Guarnieri, A.; Triunfo, M.; Scieuzo, C.; Ianniciello, D.; Tafi, E.; Hahn, T.; Zibek, S.; Salvia, R.; De Bonis, A.; Falabella, P. Antimicrobial properties of chitosan from different developmental stages of the bioconverter insect Hermetia illucens. Sci. Rep. 2022, 12, 8084. [Google Scholar] [CrossRef]
- Chang, A.K.T.; Frias, R.R.; Alvarez, L.V.; Bigol, U.G.; Guzman, J.P.M.D. Comparative antibacterial activity of commercial chitosan and chitosan extracted from Auricularia sp. Biocatal. Agric. Biotechnol. 2019, 17, 189–195. [Google Scholar] [CrossRef]
- Wang, W.; Dong, H.; Chen, Q.; Chang, X.; Wang, C.; Miao, C.; Chen, S.; Chen, L.; Wang, R.; Ge, S.; et al. Antibacterial efficacy of feline-derived lactic acid bacteria against Enteropathogenic Escherichia coli: A comprehensive in vitro analysis. Fermentation 2024, 10, 514. [Google Scholar] [CrossRef]
- Gao, Z.; Banan-Mwine Daliri, E.; Wang, J.; Liu, D.; Chen, S.; Ye, X.; Ding, T. Inhibitory effect of lactic acid bacteria on foodborne pathogens: A review. J. Food Prot. 2019, 82, 441–453. [Google Scholar] [CrossRef]
- Dai, X.; Xiong, Z.; Na, H.; Zhu, J. How does epoxidized soybean oil improve the toughness of microcrystalline cellulose filled polylactide acid composites? Compos. Sci. Technol. 2014, 90, 9–15. [Google Scholar] [CrossRef]
- Lertprapaporn, T.; Manuspiya, H.; Laobuthee, A. Dielectric improvement from novel polymeric hybrid films derived by polylactic acid/nanosilver coated microcrystalline cellulose. Mater. Today Proc. 2018, 5 Pt 2, 9326–9335. [Google Scholar] [CrossRef]
- Othman, N.A.; Adam, F.; Yasin, N.H.M. Reinforced bioplastic film at different microcrystalline cellulose concentration. Mater. Today Proc. 2021, 41 Pt 1, 77–82. [Google Scholar] [CrossRef]
- Wang, Z.; Yu, J.; Zhang, L.; Zhou, Y.; Yang, Y.; Jin, Y. Cellulose laurate ester aerogel as a novel absorbing material for removing pollutants from organic wastewater. Cellulose 2017, 24, 5069–5078. [Google Scholar] [CrossRef]
- Chang, X.X.; Mubarak, N.M.; Mazari, S.A.; Jatoi, A.S.; Ahmad, A.; Khalid, M.; Walvekar, R.; Abdullah, E.C.; Karri, R.R.; Siddiqui, M.T.H.; et al. A review on the properties and applications of chitosan, cellulose and deep eutectic solvent in green chemistry. J. Ind. Eng. Chem. 2021, 104, 362–380. [Google Scholar] [CrossRef]
- Yang, J.; Kwon, G.-J.; Hwang, K.; Kim, D.-Y. Cellulose–chitosan antibacterial composite films prepared from LiBr solution. Polymers 2018, 10, 1058. [Google Scholar] [CrossRef]
- Pongchaiphol, S.; Preechakun, T.; Raita, M.; Champreda, V.; Laosiripojana, N. Characterization of cellulose–chitosan-based materials from different lignocellulosic residues prepared by the ethanosolv process and bleaching treatment with hydrogen peroxide. ACS Omega 2021, 6, 22791–22802. [Google Scholar] [CrossRef]
- Ting, S.S.; Hussain, M.; Yaacob, N.D.; Majib, N.M.; Hamimi, S.N.; See, T.L.; Kian, T.W. Characterization and evaluation of polymer thin film composites from rice straw microcrystalline cellulose and mushroom chitosan. Malays. J. Microsc. 2024, 20, 337–350. [Google Scholar]
- Fouad, H.; Kian, L.K.; Jawaid, M.; Alotaibi, M.D.; Alothman, O.Y.; Hashem, M. Characterization of microcrystalline cellulose isolated from Conocarpus fiber. Polymers 2020, 12, 2926. [Google Scholar] [CrossRef] [PubMed]
- Asif, M.; Ahmed, D.; Ahmad, N.; Qamar, M.T.; Alruwaili, N.K.; Bukhari, S.N.A. Extraction and Characterization of Microcrystalline Cellulose from Lagenaria siceraria Fruit Pedicles. Polymers 2022, 14, 1867. [Google Scholar] [CrossRef] [PubMed]
- Hermawan, D.; Lai, T.K.; Jafarzadeh, S.J.; Gopakumar, D.A.; Hasan, M.; Owolabi, F.A.T.; Sri Aprilia, N.A.; Rizal, S.; Abdul Khalil, H.P.S. Development of seaweed-based bamboo microcrystalline cellulose films intended for sustainable food packaging applications. BioResources 2019, 14, 3389–3410. [Google Scholar] [CrossRef]
- Désiré, A.Y.; Charlemagn, N.; Claver, K.D.; Achille, T.F.; Marianne, S. Starch-based edible films of improved cassava varieties Yavo and TMS reinforced with microcrystalline cellulose. Heliyon 2021, 7, e06804. [Google Scholar] [CrossRef]
- Lubis, R.; Wirjosentono, B.; Eddyanto Septevani, A.A. Preparation, characterization and antimicrobial activity of grafted cellulose fiber from durian rind waste. Colloids Surf. A Physicochem. Eng. Asp. 2020, 604, 125311. [Google Scholar] [CrossRef]
- Sun, Y.; Wang, J.; Li, D.; Cheng, F. The recent progress of the cellulose-based antibacterial hydrogel. Gels 2024, 10, 109. [Google Scholar] [CrossRef] [PubMed]
- Hu, P.; Lai, A.; Zhou, S. Preparation and properties of antibacterial PVA@MCC composite membrane assisted by ionic liquids and DMSO. Chin. J. Chem. Eng. 2025, 79, 72–80. [Google Scholar] [CrossRef]

| LLA Content (wt%) | Char Residue at 800 °C (%) | LLA-Tmax (°C) | CS-Tmax (°C) |
|---|---|---|---|
| 50 | 25.4 | 216 | 297 |
| 60 | 20.9 | 224 | 296 |
| 70 | 18.7 | 204, 238 | 305 |
| LLA Content (wt%) | Maximum Tensile Strength (MPa) | Elongation at Break (%) | Young’s Modulus (MPa) |
|---|---|---|---|
| 50 | 11.5 ± 1.4 c | 14.7 ± 2.1 a | 110.8 ± 8.2 c |
| 60 | 6.6 ± 0.5 b | 42.6 ± 2.8 b | 26.0 ± 3.4 b |
| 70 | 2.8 ± 0.4 a | 57.4 ± 4.6 c | 7.8 ± 1.2 a |
| LLA Content (wt%) | Moisture Content (%) | Water Contact Angle (°) | Water Dissolution (%) |
|---|---|---|---|
| 50 | 2.51 ± 0.14 a | 60.12 ± 2.54 b | 9.14 ± 0.43 b |
| 60 | 3.05 ± 0.09 b | 47.25 ± 3.64 a | 8.84 ± 0.77 b |
| 70 | 3.27 ± 0.20 b | 44.31 ± 2.86 a | 7.75 ± 0.61 a |
| LLA Content (wt%) | Film Thickness (mm) | Film Opacity (mm−1) | Inhibition Zone (mm) | |
|---|---|---|---|---|
| S. aureus | E. coli | |||
| 50 | 0.69 ± 0.02 b | 1.32 ± 0.11 a | 4.0 ± 0.2 a | 1.9 ± 0.2 a |
| 60 | 0.55 ± 0.02 a | 1.39 ± 0.12 a, b | 5.3 ± 0.2 b | 2.0 ± 0.4 a |
| 70 | 0.53 ± 0.01 a | 1.48 ± 0.14 b | 6.0 ± 0.4 c | 1.8 ± 0.3 a |
| MCC Content (wt%) | Char Residue at 800 °C (%) | LLA-Tmax (°C) | CS-Tmax (°C) | MCC-Tmax (°C) |
|---|---|---|---|---|
| - | 25.4 | 216 | 297 | - |
| 5 | 25.8 | 217 | 298 | - |
| 10 | 25.6 | 217 | 298 | 364 |
| 20 | 26.4 | 213 | 299 | 366 |
| MCC Content (wt%) | Maximum Tensile Strength (MPa) | Elongation at Break (%) | Young’s Modulus (MPa) |
|---|---|---|---|
| - | 11.5 ± 1.4 a | 14.7 ± 2.1 c | 110.8 ± 8.2 a |
| 5 | 20.9 ± 1.2 b | 13.6 ± 2.2 b, c | 248.5 ± 10.5 b |
| 10 | 15.4 ± 1.8 c | 12.0 ± 1.8 b | 169.9 ± 8.4 c |
| 20 | 11.6 ± 1.5 a | 10.1 ± 1.2 a | 134.8 ± 8.8 d |
| MCC Content (wt%) | Moisture Content (%) | Water Contact Angle (°) | Water Dissolution (%) |
|---|---|---|---|
| - | 2.51 ± 0.14 a | 60.12 ± 2.54 d | 9.14 ± 0.43 c |
| 5 | 2.52 ± 0.19 a | 53.05 ± 1.85 c | 8.75 ± 0.38 b, c |
| 10 | 2.54 ± 0.03 a | 47.32 ± 3.82 b | 8.64 ± 0.56 b |
| 20 | 2.87 ± 0.10 b | 35.64 ± 3.56 a | 6.63 ± 0.15 a |
| MCC Content (wt%) | Film Thickness (mm) | Film Opacity (mm−1) | Inhibition Zone (mm) | |
|---|---|---|---|---|
| S. aureus | E. coli | |||
| - | 0.69 ± 0.02 a | 1.32 ± 0.11 a | 4.0 ± 0.2 b | 1.9 ± 0.2 b |
| 5 | 0.71 ± 0.02 a | 1.34 ± 0.14 a | 4.3 ± 0.2 b | 2.2 ± 0.3 b |
| 10 | 0.68 ± 0.03 a | 1.38 ± 0.18 a | 4.4 ± 0.3 b | 2.4 ± 0.5 b |
| 20 | 0.70 ± 0.05 a | 2.57 ± 0.15 b | 2.8 ± 0.4 a | 1.5 ± 0.3 a |
Disclaimer/Publisher’s Note: The statements, opinions and data contained in all publications are solely those of the individual author(s) and contributor(s) and not of MDPI and/or the editor(s). MDPI and/or the editor(s) disclaim responsibility for any injury to people or property resulting from any ideas, methods, instructions or products referred to in the content. |
© 2025 by the authors. Licensee MDPI, Basel, Switzerland. This article is an open access article distributed under the terms and conditions of the Creative Commons Attribution (CC BY) license (https://creativecommons.org/licenses/by/4.0/).
Share and Cite
Srihanam, P.; Phromsopha, T.; Sangdee, A.; Khotsaeng, N.; Lan, P.N.; Baimark, Y. Thermo-Compression of Thermoplastic Chitosan Films Reinforced with Microcrystalline Cellulose for Antibacterial Food Packaging Application. Polymers 2025, 17, 2460. https://doi.org/10.3390/polym17182460
Srihanam P, Phromsopha T, Sangdee A, Khotsaeng N, Lan PN, Baimark Y. Thermo-Compression of Thermoplastic Chitosan Films Reinforced with Microcrystalline Cellulose for Antibacterial Food Packaging Application. Polymers. 2025; 17(18):2460. https://doi.org/10.3390/polym17182460
Chicago/Turabian StyleSrihanam, Prasong, Theeraphol Phromsopha, Aphidech Sangdee, Nuanchai Khotsaeng, Pham Ngoc Lan, and Yodthong Baimark. 2025. "Thermo-Compression of Thermoplastic Chitosan Films Reinforced with Microcrystalline Cellulose for Antibacterial Food Packaging Application" Polymers 17, no. 18: 2460. https://doi.org/10.3390/polym17182460
APA StyleSrihanam, P., Phromsopha, T., Sangdee, A., Khotsaeng, N., Lan, P. N., & Baimark, Y. (2025). Thermo-Compression of Thermoplastic Chitosan Films Reinforced with Microcrystalline Cellulose for Antibacterial Food Packaging Application. Polymers, 17(18), 2460. https://doi.org/10.3390/polym17182460

